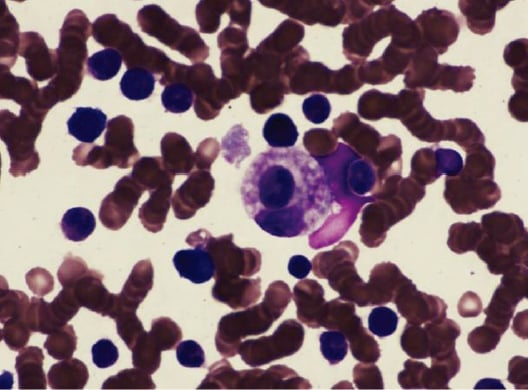
HLH骨髓涂片噬血现象：活化巨噬细胞吞噬红细胞和有核细胞

在门诊和病房里,我最怕听到的一句话是:“化疗或免疫治疗后发烧了,先吃点抗生素扛一扛。”很多时候,发热确实可能是感染或药物反应;但在免疫检查点抑制剂(ICIs)时代,有一种更隐蔽、更凶险、却又“越早识别越能救回来”的并发症,需要患者和家属都知道:噬血细胞性淋巴组织细胞增生症(HLH)。它不是普通发烧,而是免疫系统“刹车失灵”后引发的全身炎症风暴,进展快、风险高,但只要识别及时,规范免疫抑制治疗往往能迅速扭转局面。
这篇文章我会用一例乳腺癌免疫联合化疗后发生HLH的真实诊疗线索,带你把“什么时候要怀疑HLH、要做哪些检查、医生通常怎么治、家属在家如何观察和准备”讲清楚。尤其如果你或家人正在使用特瑞普利单抗、帕博利珠单抗等PD-1/PD-L1药物,这些内容可能非常关键。
一、先把概念讲透:HLH到底是什么?为什么免疫治疗会诱发?
HLH可以理解为一种“免疫系统过度亢奋导致的系统性炎症综合征”。正常情况下,免疫系统像有油门也有刹车:发现异常细胞就加速攻击,任务完成就降温收兵。免疫检查点抑制剂的作用,是把肿瘤“踩住免疫刹车”的那只脚挪开,让T细胞更积极地打肿瘤。
问题在于:当“刹车”解除得过猛或个体过敏感时,T细胞可能过度活化,释放大量炎症信号(如IFN-γ、TNF-α等),进一步把巨噬细胞系统也“点燃”。巨噬细胞一旦异常激活,就可能出现典型的“噬血”现象:把红细胞、白细胞、血小板等血细胞当成“需要清理的目标”吞噬,最终造成高烧、血细胞减少、肝功能异常、凝血紊乱、铁蛋白极高、脾脏肿大等一系列表现。
HLH按病因可分为:原发性(遗传性)和继发性(获得性)。成人更常见的是继发性HLH,诱因包括感染、恶性肿瘤、风湿免疫病,以及近年来越来越受到关注的:免疫检查点抑制剂相关HLH(ICI-HLH)。
二、为什么乳腺癌患者也要警惕?这不是“罕见到不用管”的事
从现有分析数据看,ICI-HLH在全部HLH中占比约5.7%,整体死亡率约15.3%,虽然低于经典HLH报道的20%~40%,但仍然是需要争分夺秒处理的重症。更重要的是:ICI-HLH对糖皮质激素往往更敏感,有分析提示53.5%患者单用激素就能有效缓解——这意味着“早识别、早用对药”,可能直接改变结局。
乳腺癌领域的ICI-HLH报道确实少,但“少”不等于“不会发生”。当免疫治疗逐渐进入更多乳腺癌治疗策略(尤其某些人群会尝试免疫联合方案),这种风险就需要被患者和家属纳入“必须知道的急症清单”。
三、真实病例带你抓重点:免疫联合化疗后13天高热,关键线索是“铁蛋白”
1)患者基础情况
患者女性,60岁,左侧乳腺浸润性乳腺癌,分型为Luminal B型,HER2阴性,临床分期ⅢA期。既往无糖尿病、高血压、自身免疫病史,否认慢性感染史。
她先接受TE方案(紫杉醇脂质体+多柔比星脂质体)新辅助化疗4周期后部分缓解。随后为进一步治疗,接受免疫联合化疗1周期:特瑞普利单抗240 mg + 白蛋白紫杉醇350 mg + 顺铂100 mg。
2)发病过程:持续高热,抗生素无效
治疗后约2周出现发热,伴畏寒寒战、干咳、乏力、纳差,体温最高40℃。院外口服与静脉头孢治疗无效后入院。入院时ECOG 2分,查体提示轻度脾大(脾肋下约1 cm)。
3)化验与影像:HLH的“组合拳”特征出现了
入院后经验性抗感染(万古霉素+亚胺培南),同时完善检查。关键实验室结果包括:
- 血细胞减少:血红蛋白87 g/L,血小板68×10^9/L(白细胞5.2×10^9/L)。
- 肝酶与组织损伤指标升高:AST 190 U/L,LDH 1532 U/L。
- 凝血与炎症异常:纤维蛋白原1.31 g/L降低,D-二聚体>10000 μg/L,CRP 124.77 mg/L。
- 甘油三酯升高:2.74 mmol/L。
- 最关键的线索:铁蛋白>30000 μg/L(远高于正常12~150 μg/L)。
病原学方面,呼吸道病原体与EB病毒核酸阴性,血培养阴性;影像学未见明确感染灶。腹部CT提示脾大。

腹部CT提示脾脏增大(该病例脾长径约13.58 cm、厚径约46.56 mm)。
4)进一步确诊:骨髓噬血+sCD25+NK活性
在排除明确感染与肿瘤进展后,血液科会诊建议完善骨髓穿刺、sCD25与NK细胞活性。结果显示:
- 骨髓穿刺见噬血现象;
- sCD25 7380.30 ng/L(参考<6400 ng/L);
- NK细胞活性 16.76%(正常20%~40%)。
骨髓涂片可见活化巨噬细胞吞噬红细胞及有核细胞,提示典型噬血表现。
最终,该患者符合HLH-2004诊断标准8项中的7项(发热、脾大、两系血细胞减少、低纤维蛋白原、铁蛋白升高、骨髓噬血、sCD25升高),HScore 312分(≥169分提示HLH概率≥90%)。
四、患者最需要记住的“识别口诀”:免疫治疗后发热,别只盯感染
HLH的可怕之处是:症状非常像感染、像肿瘤进展、像化疗反应,因此容易被“先按感染治”耽误。结合文献与该病例,我建议患者家属重点记住以下高危信号(尤其在使用PD-1/PD-L1药物后几天到数月内):
1)三大常见起始表现
- 持续高热:反复39℃以上,退热药效果差,或抗生素治疗无明显改善。
- 血细胞减少:贫血、血小板下降、白细胞下降(可为一系或多系)。
- 铁蛋白显著升高:很多ICI-HLH患者会出现“非常高”的铁蛋白,常成为破局线索。
2)其他需要同时关注的危险信号
- 肝功能异常(转氨酶升高)、LDH升高;
- 凝血异常(纤维蛋白原下降、D-二聚体升高、容易出血或淤青);
- 脾脏肿大、腹胀或左上腹不适;
- 意识改变、嗜睡、抽搐(提示中枢累及,属于急危重症)。
重要提醒:化疗也会造成骨髓抑制,但通常不解释“极度高铁蛋白+噬血现象”这种组合。若你看到“高烧+血小板掉得快+铁蛋白高得离谱”,一定要把HLH放进鉴别清单里。
五、医生如何确诊:HLH-2004与HScore到底在看什么?
目前临床常用两套工具:
1)HLH-2004标准(8条,满足≥5条)
该病例满足其中7条。对患者而言,不必背诵每一条,但要知道它强调的是“全身炎症+免疫过激+血液系统受损”的综合证据。
2)HScore(≥169分提示概率≥90%)
它把发热、脾大、细胞减少、铁蛋白、甘油三酯、纤维蛋白原、骨髓噬血、免疫抑制因素等量化,帮助快速判断。
3)常见需要补齐的检查清单(患者可用来与医生沟通)
- 铁蛋白(非常关键);
- 甘油三酯、纤维蛋白原、凝血全套、D-二聚体;
- 肝肾功能、LDH;
- sCD25、NK细胞活性;
- 骨髓穿刺(寻找噬血现象,同时排除血液系统恶性肿瘤等);
- 病原学排查(如EBV、血培养、呼吸道病原体等),因为感染也可能触发HLH,且需要与免疫相关毒性做区分。
六、治疗怎么做?核心是“停药+迅速压住免疫风暴”
在ICI-HLH中,治疗逻辑通常是三步:
- 立即停用免疫检查点抑制剂(在医生评估下执行);
- 尽快启动免疫抑制:糖皮质激素是一线核心;
- 重症或激素不足时升级方案:可考虑依托泊苷、托珠单抗、环孢素等(由专科团队评估)。
指南层面,EULAR/ACR在免疫相关不良事件管理中强调:在停用ICI基础上,糖皮质激素作为一线免疫抑制治疗;对重症或激素疗效不佳者,可加用或换用依托泊苷、托珠单抗或环孢素等。
这位患者是怎么被救回来的?
该病例在入院第3天即开始甲泼尼龙静脉冲击(d1~d3,100 mg/d)。治疗2天后精神状态好转,血常规、肝功能、凝血等明显改善。之后逐步减量并序贯口服,同时加用小剂量依托泊苷口服(50 mg/次,每周2次,持续2周)以巩固疗效。出院1个月复查血常规、肝肾功能、凝血、铁蛋白及影像检查均未见异常。
这里我特别想强调一个对家属很重要的现实点:ICI-HLH对激素相对敏感,文献分析提示约53.5%患者激素单药有效,但这并不意味着可以“在家自己吃激素”。激素的剂量、给药途径、减量节奏,以及是否需要联合其他免疫抑制药,都必须由有经验的肿瘤科/血液科团队评估,因为错误用药同样可能带来严重感染等风险。
七、居家管理与就医行动清单:把“可能救命的窗口期”抓住
1)在家如何监测?(建议写进手机备忘录)
- 体温:每天至少早晚各一次;一旦≥38.5℃并持续或反复,记录时间、最高温、退热效果。
- 出血与淤青:刷牙出血、鼻出血、皮肤瘀点瘀斑增多,提示血小板或凝血问题。
- 精神状态:明显嗜睡、反应慢、意识模糊属于危险信号。
- 呼吸与胸闷:呼吸急促、气短要警惕感染或炎症累及。
- 尿量与颜色:少尿、茶色尿需要尽快评估。
2)出现哪些情况应立即去急诊/尽快住院?
- 持续高热(尤其≥39℃)且抗生素或退热药效果差;
- 高热+乏力明显+食欲极差,或伴寒战;
- 任何出血倾向(鼻出血、牙龈出血、黑便、血尿等);
- 意识改变、抽搐;
- 实验室提示血小板快速下降或肝酶、凝血快速恶化(若你手里有报告)。
3)到医院你可以主动提出的“高价值信息”
- 把你正在用的免疫药物名称、给药日期、联合化疗方案写清楚(例如该病例为“特瑞普利单抗+白蛋白紫杉醇+顺铂”)。
- 明确告诉医生:担心免疫相关不良事件,尤其HLH,希望评估铁蛋白、纤维蛋白原、甘油三酯、sCD25、NK活性,必要时骨髓穿刺。
- 带上所有既往血常规、肝功能、凝血指标,方便判断“下降速度”。
八、关于药物可及性与“下一步怎么办”:治疗不止一条路,但要有导航
对很多家庭来说,最难的是两件事:第一,迅速分辨这是感染还是免疫毒性;第二,在免疫抑制控制HLH的同时,肿瘤治疗还能怎么接续。这需要肿瘤科、血液科、感染科等多学科协作,且方案高度个体化。
在药物可及性方面,不同地区对免疫治疗药物、支持治疗药物、以及某些用于处理免疫毒性的药物,获取速度和渠道可能不同。现实中,很多患者会面临“本地一时配不到、审批慢、信息不对称”的压力,而HLH这种病往往不允许你等。
九、我给正在用免疫治疗的乳腺癌家庭一句实用建议
把“HLH预警卡”提前准备好:列出你正在使用的免疫药物、最近一次输注日期、主治医生联系方式、最近一次血常规/肝功/凝血结果。一旦出现持续高热,第一时间把这张卡交给急诊医生,会显著缩短判断时间。
同时请记住:免疫治疗带来的获益是真实存在的,但免疫相关重症不良事件也同样真实。最好的策略不是恐惧,而是提前知道风险、学会识别、把握就医时机。
十、你可以如何使用MedFind的帮助
如果你或家人在免疫治疗过程中出现持续发热、血象下降、铁蛋白异常升高等情况,或者已经被提示怀疑HLH,我建议你尽快做两件事:
- 使用MedFind的AI辅助问诊与方案解读:把用药时间线、化验单(血常规、肝功、凝血、铁蛋白等)与影像结果整理后提交,我们可以帮助你把关键风险点“翻译”成可与医生高效沟通的清单,避免在急诊反复兜圈。
- 了解药物可及性与跨境直邮选项:当你需要某些关键支持用药、而本地短期难以获取时,跨境直邮能为部分家庭争取时间窗口。具体用药必须以医院医嘱为准,但“把药及时拿到手”往往是治疗能否顺利执行的前提。
我始终相信:面对免疫治疗的复杂性,患者最需要的不是更多焦虑,而是一份清晰、可执行、能在关键时刻派上用场的路线图。
参考文献信息
[1] Sharma P, Goswami S, Raychaudhuri D, et al. Immune checkpoint therapy-current perspectives and future directions. Cell, 2023, 186(8):1652-1669.
[2] Ramos-Casals M, Brito-Zerón P, López-Guillermo A, et al. Adult haemophagocytic syndrome. Lancet, 2014, 383(9927):1503-1516.
[3] Debaugnies F, Mahadeb B, Ferster A, et al. Performances of the H-score for diagnosis of hemophagocytic lymphohistiocytosis in adult and pediatric patients. Am J Clin Pathol, 2016, 145(6):862-870.
[4] Diaz L, Jauzelon B, Dillies AC, et al. Hemophagocytic lymphohistiocytosis associated with immunological checkpoint inhibitors: a pharmacovigilance study. J Clin Med, 2023, 12(5):1985.
[5] Olmes GL, Nigdelis MP, Hamoud BH, et al. Secondary hemophagocytic lymphohistiocytosis associated with adjuvant pembrolizumab therapy in a young patient with triple-negative breast cancer: a case report with literature review. Arch Gynecol Obstet, 2025, 312(5):1813-1820.
[6] Kennedy LB, Salama AKS. A review of cancer immunotherapy toxicity. CA Cancer J Clin, 2020, 70(2):86-104.
[7] Demaria O, Cornen S, Daëron M, et al. Harnessing innate immunity in cancer therapy. Nature, 2019, 574(7776):45-56.
[8] Walmsley CS, Schoepflin Z, De Brabandt C, et al. Hemophagocytic lymphohistiocytosis associated with immune checkpoint inhibitor use: a review of the current knowledge and future directions. Blood Cells Mol Dis, 2025, 110:102896.
[9] Rajapakse P, Andanamala H. Hemophagocytic lymphohistiocytosis secondary to immune checkpoint inhibitor therapy. World J Oncol, 2022, 13(2):49-52.
[10] Imashuku S, Morimoto A, Ishii E. Virus-triggered secondary hemophagocytic lymphohistiocytosis. Acta Paediatr, 2021, 110(10):2729-2736.
[11] Fukaya S, Yasuda S, Hashimoto T, et al. Clinical features of haemophagocytic syndrome in patients with systemic autoimmune diseases: analysis of 30 cases. Rheumatology (Oxford), 2008, 47(11):1686-1691.
